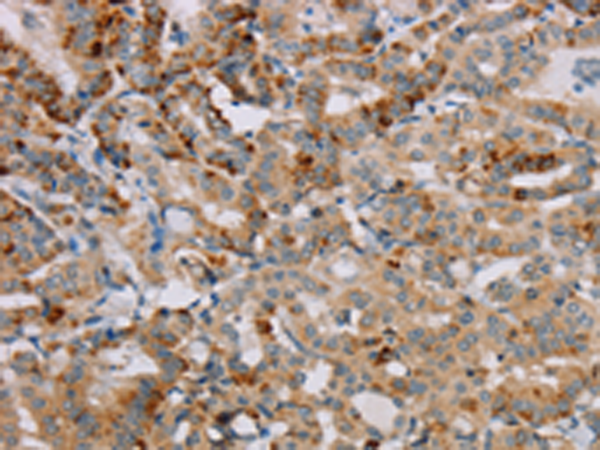
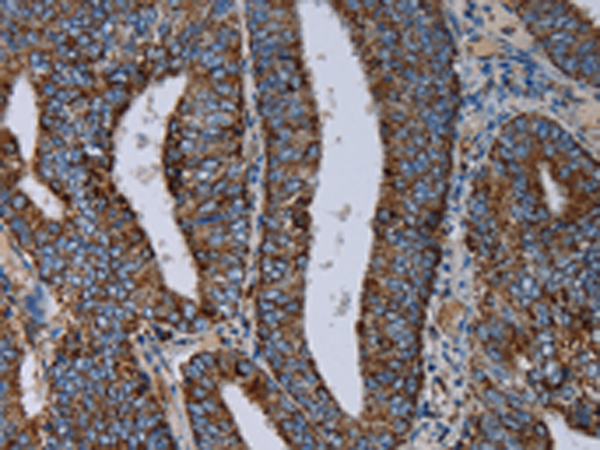
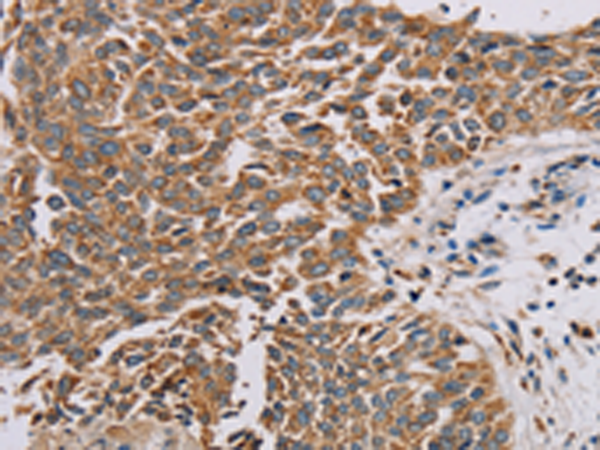

-
分类: 科研抗体货号: P08530别名: M96; PCL2; TDRD19A; dJ976O13.2应用: WB反应种属: Human, Mouse
-
分类: 科研抗体货号: P08540别名: NOS2; ZC2HC12B应用: IHC反应种属: Human
-
分类: 科研抗体货号: P08529别名: ZRF; MTF-1应用: IHC反应种属: Human
-
分类: 科研抗体货号: P08539别名: Bex; NADE; HGR74; NGFRAP1; DXS6984E应用: IHC反应种属: Human
-
分类: 科研抗体货号: P08558别名: CI-13kA; CI13KDA; CI-13kD-A应用: IHC反应种属: Human, Mouse, Rat
-
分类: 科研抗体货号: P08538别名: MBS; M130; MYPT1应用: WB,IHC反应种属: Human, Mouse, Rat
-
分类: 科研抗体货号: P08557别名: AQDQ; CI-18应用: WB,IHC反应种属: Human, Mouse, Rat
-
分类: 科研抗体货号: P08537别名: PVALB; myoglobgin应用: WB,IHC反应种属: Human, Mouse, Rat
-
分类: 科研抗体货号: P08556别名: PSST; CI-20; MY017; CI-20KD应用: IHC反应种属: Human, Mouse
-
分类: 科研抗体货号: P08536别名: MyoGEF应用: WB,IHC反应种属: Human, Mouse

鄂公网安备42018502007531号
鄂公网安备42018502007531号

